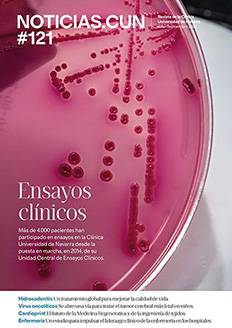

Revista NoticiasCUN nº 134
Publicaciones corporativas de la Clínica

Otras Publicaciones corporativas
NoticiasCUN nº 133

NoticiasCUN nº 132

NoticiasCUN nº 131

NoticiasCUN nº 130

NoticiasCUN nº 129

NoticiasCUN nº 128

NoticiasCUN nº 127

NoticiasCUN nº 126

NoticiasCUN nº 125

NoticiasCUN nº 124

NoticiasCUN nº 123

NoticiasCUN nº 122

NoticiasCUN nº 121
NoticiasCUN nº 120

NoticiasCUN nº 119

NoticiasCUN nº 118

NoticiasCUN nº 117

NoticiasCUN nº 116

NoticiasCUN nº 115

NoticiasCUN nº 114

NoticiasCUN nº 113

NoticiasCUN nº 112

NoticiasCUN nº 111

NoticiasCUN nº 110

NoticiasCUN nº 109

NoticiasCUN nº 108

NoticiasCUN nº 107

NoticiasCUN nº 106

NoticiasCUN nº 105

NoticiasCUN nº 104

NoticiasCUN nº 103

NoticiasCUN nº 102

NoticiasCUN nº 101

NoticiasCUN nº 100



